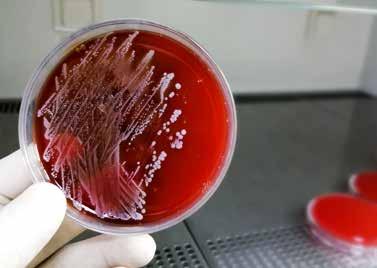

10 minute read
PORTATORI DI STAPHYLOCOCCUS AUREUS E RISCHIO DI CONTAMINAZIONE ALIMENTARE
Eseguire dei test di screening tra gli operatori alimentari aiuterebbe a individuare i portatori sani del patogeno e a ridurre il rischio di contaminazione del prodotto
Lo Staphylococcus aureus (S. aureus) è un batterio Gram-positivo riconosciuto come il patogeno umano in grado di colonizzare la cute e le mucose causando una pletora di infezioni opportunistiche, da lievi (come impetigine e cellulite) a più gravi (come endocarditi e batteriemie). Oltre alla cute, la colonizzazione di questo commensale può interessare diversi siti corporei come l’intestino retto, il tratto digerente e l’area inguinale ma sono le narici anteriori il suo “serbatoio” principale. I portatori sani di S. aureus, cioè quei soggetti colonizzati dal batterio che non manifestano alcun sintomo, possono essere classificati in:
• portatori persistenti quando la colonizzazione non scompare (quindi il rischio di infezione è molto alto) e corrispondono al 10-20% della popolazione generale;
• portatori intermittenti quando, invece, i periodi di colonizzazione si alternano alla scomparsa del commensale dalla cute e corrispondono al 30-50% della popolazione.
La colonizzazione può favorire l’insorgenza di infezioni da S. aureus e questa relazione è stata confermata dall’identificazione di genotipi condivisi tra i ceppi isolati nelle narici e quelli riscontrati nei siti di infezione. Inoltre, la colonizzazione sembra essere influenzata dalla competizione intra-specie tra ceppi MSSA (meticillino-sensibili) e ceppi MRSA (meticillino-resistenti). I primi, infatti, giocano un ruolo protettivo ostacolando l’inserimento di molto più aggressivi e virulenti [1].
S. aureus colonizza sia l’epitelio delle narici anteriori attraverso l’azione di molecole adesive come il fattore di aggregazione B (ClfB) e il determinante di superficie A (isda). Questi fattori interagiscono con la loricrina e le citocheratine che sono tra le principali proteine espresse dai cheratinociti dello strato corneificato dell’epitelio. Al contrario, la colonizzazione della cavità nasale interna sembra essere guidata dall’acido teicoico presente sulla parete cellulare dello stafilococco che interagendo con il recettore dello scavenger di tipo F (SREC-1) delle cellule epiteliali determina la persistenza del patogeno nel sito colonizzato. Conoscere la localizzazione dello S. aureus all’interno della cavità nasale è estremamente importante per eseguire correttamente il tampone e quindi ottenere la massima sensibilità del test.
La colonizzazione è influenzata anche dalla composizione della comunità microbica all’interno della cavità nasale. Ad esempio, in vitro è stato osservato che Corynebacterium accolens sembra promuovere la crescita di S. aureus (come conseguenza di un adattamento reciproco), al contrario Corynebacterium pseudodiphteriticum ne inibisce la crescita. infatti, alcune specie batteriche sono in grado di produrre delle molecole con azione battericida contro lo stafilococco, come nel caso dello Streptococcus pneumoniae e dello Staphylococcus lugdunensis che producono, rispettivamente, H2O2 e lugdunina [2].
I portatori non corrono solo il rischio di acquisire ceppi endogeni o esogeni ma possono anche rappresentare essi stessi un rischio che è quello di diffondere nell’ambiente circostante i ceppi da cui risultano colonizzati. Ecco perché durante la manipolazione degli alimenti, i portatori possono essere vettori di diffusione del patogeno e la scarsa igiene delle loro mani è ritenuta la principale causa di contaminazione. L’intossicazione e la tossinfezione alimentare causata da S. aureus avviene dopo aver ingerito l’alimento contaminato. In particolare, l’intossicazione si verifica quando l’alimento è contaminato dal patogeno attivo mentre la tossinfezione coinvolge gli alimenti dove la presenza del patogeno raggiunge livelli elevati tanto da produrre l’enterotossine. Queste, sfuggendo all’attività degli enzimi proteolitici, riescono ad attraversare indisturbate il tratto gastrointestinale. Qui vengono riassorbite innescando nausea e/o vomito a cui si accompagnano crampi addominali e diarrea, che solitamente compaiono entro 2-8 ore dal consumo del cibo contaminato con un decorso benigno dopo 12-48 ore. La gravità della tossinfezione dipende dalla suscettibilità del soggetto e dalla quantità di enterotossine ingerite (approssimativamente sono sufficienti 20-100 ng). I casi in cui è richiesto il ricovero in ospedale sono rari e riguardano i neonati, gli anziani o i pazienti debilitati [3].
Dall’ultimo rapporto annuale sulle zoonosi “One Health” dell’Unione Europea pubblicato dall’EFSA (Autorità Europea per la Sicurezza Alimentare) e dall’ECDC (Centro Europeo per la Prevenzione e il Controllo delle Malattie), nel 2021 si sono verificati 64 focolai causati dalle tossine dello S. aureus. I casi di tossinfezione umana sono stati 640 ma solo per l’8% di questi è stato necessario il ricovero in ospedale. È importante sottolineare che la maggior parte delle persone guarisce spontaneamente senza avere la necessità di ricorrere all’assistenza medica; pertanto, l’incidenza reale dei casi sarà inevitabilmente sottostimata [4].
Gli alimenti più comunemente associati a casi di intossicazione alimentare da S. aureus sono: carne e derivati, pollame e prodotti a base di uova, latte non pastorizzato e prodotti lattiero-caseari. A questi seguono le insalate, i prodotti da forno con farciture di creme, torte e sandwich. Una volta avvenuta la contaminazione dell’alimento sono le condizioni di conservazione inadeguate che consentono allo S. aureus di crescere e raggiungere la densità cellulare necessaria per produrre enterotossine. La temperatura, il pH, l’attività dell’acqua libera, l’ossigeno, il potenziale redox e la concentrazione di sale influenzano la crescita del batterio e la conseguente produzione di enterotossine. Ma tra tutti questi, il fattore più critico è la temperatura perché le enterotossine resistono al trattamento termico della cottura che quindi risulta inutile. Alla luce di questo, il rispetto delle norme igieniche durante la lavorazione diventa fondamentale perché consente di ridurre la presenza del patogeno e delle enterotossine fin dalle prime fasi del processo [3].
Gli operatori alimentari e la contaminazione crociata
La contaminazione crociata, cioè il trasferimento di patogeni da fonti contaminate che possono comprendere alimenti, superfici e operatori, è stata identificata come una delle cause dei focolai di tossinfezioni alimentari causate da S. aureus. Gli operatori alimentari che sono portatori del patogeno possono contaminare le loro mani e altre parti del corpo e agire come responsabili di contaminazione crociata in qualsiasi fase della catena di produzione. Per prevenire la diffusione di S. aureus (lo stesso discorso è valido anche per altri patogeni) lavare le mani con acqua calda e sapone risulta sempre la pratica più facile e importante da attuare. Qualora non sia possibile accedere a lavaggio, magari durante le ore di lavoro può capitare di non avere la possibilità di effettuare un lavaggio frequente, è fortemente raccomandato l’utilizzo di un disinfettante a base alcolica, preferibilmente sotto forma di gel. Anche l’uso di guanti è considerato un efficace metodo di riduzione del trasferimento di contaminanti dalle mani all’alimento purché si faccia attenzione a ricambiarli frequentemente per evitare l’accumulo di contaminanti sulla loro superficie [5].
Gli addetti alla manipolazione degli alimenti che lavorano nella stessa area di un impianto industriale possono entrare in contatto fisico tra di loro oppure con oggetti condivisi e aumentare il rischio di contaminazione sia tra loro stessi che tra loro e l’alimento in lavorazione. Una volta infettati questi operatori possono trasmettere il ceppo alle persone con cui vivono o comunque entrano in contatto al di fuori della vita lavorativa e quindi contribuire alla diffusione di quelle infezioni note per essere causate da ceppi acquisiti in comunità (CA-MRSA, Community-acquired methicillin-resistant S. aureus).
Inoltre, lo S. aureus ha la capacità di aderire alle superfici che prendono contatto con gli alimenti e produrre biofilm. Dopo l’adesione, le cellule batteriche iniziano a moltiplicarsi producendo una matrice extracellulare di sostanze polimeriche che consente al batterio di assorbire nutrienti dall’ambiente e resistere ai disinfettanti. Per questo motivo l’adesione e la formazione di biofilm rappresentano due importanti fattori di virulenza che permettono allo S. aureus di sopravvivere su diverse superfici, promuovendo la colonizzazione di ambienti ostili e aumentando il rischio di contaminazione crociata. Le temperature e l’impiego di nutrienti durante la trasformazione industriale degli alimenti sono condizioni ottimali per la sopravvivenza di diverse comunità microbiche e i biofilm formati da specie batteriche diverse rafforzano la colonizzazione e aumentano la persistenza dello S. aureus all’interno dell’alimento [6]. Nel corso degli ultimi anni la letteratura ha documentato numerosi casi di contaminazione crociata originata da un operatore portatore sano. Per esempio, nel 2015 in Umbria si verificò un focolaio di tossinfezione alimentare che coinvolse 24 persone che iniziarono a manifestare i sintomi tipici dopo aver consumato il loro pasto al ristorante. Dall’analisi del cibo consumato emerse che una contaminazione da S. aureus nella crema Chantilly del dolce. Non solo, all’interno dell’alimento furono rintracciati elevati livelli dell’enterotossina SEA e ben 5 dipendenti del ristorante risultarono colonizzati dallo S. aureus. In particolare, i tre ceppi produttori dell’enterotossina SEA che erano stati isolati dal dolce, dalle superfici e dalla cute del cuoco avevano lo stesso profilo clonale (individuato tramite la tecnica PFGE, pulsed-field gel electrophoresis) e appartenevano a un biotipo umano. Questi dati suggerirono che a causare il focolaio fosse stato quindi un dipendente del ristorante che aveva preso contatto con l’alimento, contaminandolo [7]. Studi come quello appena descritto confermano la necessità di eseguire programmi di monitoraggio degli operatori alimentari per ridurre al minimo il rischio di contaminazione crociata. Questi programmi potrebbero essere molto utili non solo per aumentare la sicurezza alimentare ma anche per ridurre la diffusione di ceppi responsabili di infezioni comunitarie.
Decolonizzazione nasale e
prevenzione
La decolonizzazione nasale è la strategia più importante per prevenire la trasmissione di S. aureus, e tra i tanti agenti antibiotici disponibili la mupirocina è quello attualmente considerato più efficace. Questo antibiotico è naturalmente prodotto dal batterio Pseudomonas fluorescens e ha una buona attività anche contro alcuni streptococchi. La mupirocina ha un’efficacia clinica del 90-94% dopo due applicazioni al giorno per 7 giorni direttamente nelle narici anteriori. Tuttavia, un’applicazione prolungata può causare lo sviluppo di meccanismi di resistenza che compromettono la decolonizzazione nasale. Alla luce di ciò, la ricerca scientifica si sta concentrando su trattamenti alternativi come, ad esempio, l’impiego di antibiotici per via orale che sono utilizzati anche quando la colonizzazione interessa altri siti corporei e non solo le narici. Un’altra possibilità è quella di combinare antibiotici e farmaci antisettici che finora hanno sempre mostrato un buon livello di efficacia [8].
Gli studi in corso sulle nuove molecole hanno portato alla luce risultati promettenti negli esperimenti di laboratorio, ma non ci sono ancora studi clinici che possano confermarne l’efficacia anche nell’uomo. Tra queste, la lisostafina (un enzima batterico in grado di agire sulla parete cellulare dello stafilococco), e l’epidermicina (una batteriocina con attività sui Gram-positivi) sembrano essere molecole più efficaci della mupirocina [9].
Ma la ricerca di opzioni di trattamento alternative si fa strada anche tra le molecole di origine vegetale e nello specifico tra i terpenoidi, i flavonoidi e i composti organosolfuri. Ne sono un esempio il terpinen-4-olo che è un olio essenziale estratto dalle foglie dell’albero del tè la cui efficacia contro lo S. aureus sembra essere dovuta alla sua capacità di interferire con la sintesi della parete cellulare [10]. Tra i flavonoidi, il licocalcone A, che viene estratto dalla radice della liquirizia, ha mostrato un’elevata efficacia contro i ceppi MRSA mentre il citrox, un bioflavonoide naturalmente estratto dalle arance amare, sembra essere efficace nel trattamento di quei ceppi in grado di produrre biofilm [11]. Tuttavia, nell’ampio pannello di molecole naturali in corso di valutazione è l’allicina quella che riceve maggiore interesse perché oltre ad avere attività antibatterica mostra anche proprietà antivirulenti e questo potrebbe essere un valido aiuto nel trattamento delle infezioni causate da ceppi di S. aureus che producono tossine [12].
La possibilità di disporre di altri trattamenti di pari o superiore efficacia rispetto alla mupirocina è ancora ben lontana, pertanto, è ancora più fondamentale attuare strategie di prevenzione. Le prime misure da rispettare per prevenire la contaminazione alimentare da S. aureus sono il mantenimento della catena del freddo e soprattutto il monitoraggio degli operatori addetti alla manipolazione degli alimenti. L’applicazione di programmi di screening all’interno degli stabilimenti industriali rappresenta uno strumento molto utile per individuare tempestivamente eventuali portatori sani evitando, quindi, casi di contaminazione crociata da operatore ad alimento e da operatore a operatore. Quest’ultimo punto aiuterebbe a ridurre l’impiego di antibiotici per la decolonizzazione frenando lo sviluppo di meccanismi di resistenza. Da non sottovalutare poi l’importanza della prevenzione indossando guanti, mascherine e cuffie per capelli durante la manipolazione degli alimenti e a seguire corrette procedure di disinfezione e sterilizzazione degli ambienti e delle attrezzature.
Conclusioni
La manipolazione degli alimenti da parte di operatori portatori sani di S. aureus si conferma la principale causa di focolai di tossinfezione. La mancanza di programmi di screening all’interno delle varie fasi della catena alimentare, la rottura della catena del freddo e le scarse misure igieniche rappresentano dei punti critici nella gestione di un problema che con il passare degli anni assume sempre più interesse in termini di salute pubblica. Attualmente il trattamento antibiotico a base di mupirocina applicata direttamente nelle narici anteriori è quello più efficace per la decolonizzazione dei portatori sani. Ma l’uso prolungato può promuovere lo sviluppo di meccanismi di resistenza e al momento non sono disponibili dati clinici sull’efficacia delle molecole alternative in studio. Pertanto, le misure preventive rappresentano l’unica strategia da mettere in pratica per evitare casi di contaminazione crociata e ridurre la diffusione dei ceppi tra gli operatori e all’interno della comunità. (D. B.).
Bibliografia
1. Ryu, S.; Song, P.I.; Seo, C.H.; Cheong, H.; Park, Y. Colonization and Infection of the Skin by S. Aureus: Immune System Evasion and the Response to Cationic Antimicrobial Peptides. Int. J. Mol. Sci. 2014, doi:10.3390/ijms15058753.
2. Krismer, B.; Weidenmaier, C.; Zipperer, A.; Peschel, A. The Commensal Lifestyle of Staphylococcus aureus and its Interactions with the Nasal Microbiota. Nat Rev Microb. 2017, doi:10.1038/nrmicro.2017.104
3. Hennekinne, J.A.; De Buyser, M.L.; Dragacci, S. Staphylococcus Aureus and Its Food Poisoning Toxins: Characterization and Outbreak Investigation. FEMS Microbiol. Rev. 2012, 36, 815–836, doi:10.1111/ j.1574-6976.2011.00311.x.
4. Food, E.; Authority, S. The European Union One Health 2021 Zoonoses Report. EFSA J. 2022, 20, doi:10.2903/j.efsa.2022.7666.
5. Yap, M.; Chau, M.L.; Hartantyo, S.H.P.; Oh, J.Q.; Aung, K.T.; Gutiérrez, R.A.; Ng, L.C. Microbial Quality and Safety of Sushi Prepared with Gloved or Bare Hands: Food Handlers’ Impact on Retail Food Hygiene and Safety. J. Food Prot. 2019, doi:10.4315/0362-028X.JFP-18-349.
6. Gutiérrez, D.; Delgado, S.; Vázquez-Sánchez, D.; Martínez, B.; Cabo, M.L.; Rodríguez, A.; Herrera, J.J.; García, P. Incidence of Staphylococcus Aureus and Analysis of Associated Bacterial Communities on Food Industry Surfaces. Appl. Environ. Microbiol. 2012, 78, 8547–8554, doi:10.1128/AEM.02045-12.
7. Ercoli, L.; Gallina, S.; Nia, Y.; Auvray, F.; Primavilla, S.; Guidi, F.; Pierucci, B.; Graziotti, C.; Decastelli, L.; Scuota, S. Investigation of a Staphylococcal Food Poisoning Outbreak from a Chantilly Cream Dessert, in Umbria (Italy). Foodborne Pathog. Dis. 2017, 14, 407–413, doi:10.1089/fpd.2016.2267.
8. Sakr, A., Bregeon, F., Rolain, J. M., & Blin, O. Staphylococcus aureus nasal decolonization strategies: A review. In Expert review of anti-infective therapy. 2019 doi.org/10.1080/14787210.2019.1604220
9. Mercer, D.K.; Katvars, L.K.; Hewitt, F.; Smith, D.W.; Robertson, J.; Neil, D.A.O. Crossm. 2017.
10. Cordeiro, L.; Figueiredo, P.; Souza, H.; Sousa, A.; Andrade-Júnior, F.; Medeiros, D.; Nóbrega, J.; Silva, D.; Martins, E.; Barbosa-Filho, J.; et al. Terpinen-4-Ol as an Antibacterial and Antibiofilm Agent against Staphylococcus Aureus. Int. J. Mol. Sci. 2020, doi:10.3390/ ijms21124531.
11. Wu, S.C.; Yang, Z.Q.; Liu, F.; Peng, W.J.; Qu, S.Q.; Li, Q.; Song, X. Bin; Zhu, K.; Shen, J.Z. Antibacterial Effect and Mode of Action of Flavonoids From Licorice Against Methicillin-Resistant Staphylococcus Aureus. Front. Microbiol. 2019, 10, 1–14, doi:10.3389/fmicb.2019.02489.
12. Loi, V. Van; Huyen, N.T.T.; Busche, T.; Tung, Q.N.; Gruhlke, M.C.H.; Kalinowski, J.; Bernhardt, J.; Slusarenko, A.J.; Antelmann, H. Staphylococcus Aureus Responds to Allicin by Global S-Thioallylation – Role of the Brx/BSH/YpdA Pathway and the Disulfide Reductase MerA to Overcome Allicin Stress. Free Radic. Biol. Med. 2019, 139, 55–69, doi:10.1016/j.freeradbiomed.2019.05.018.









